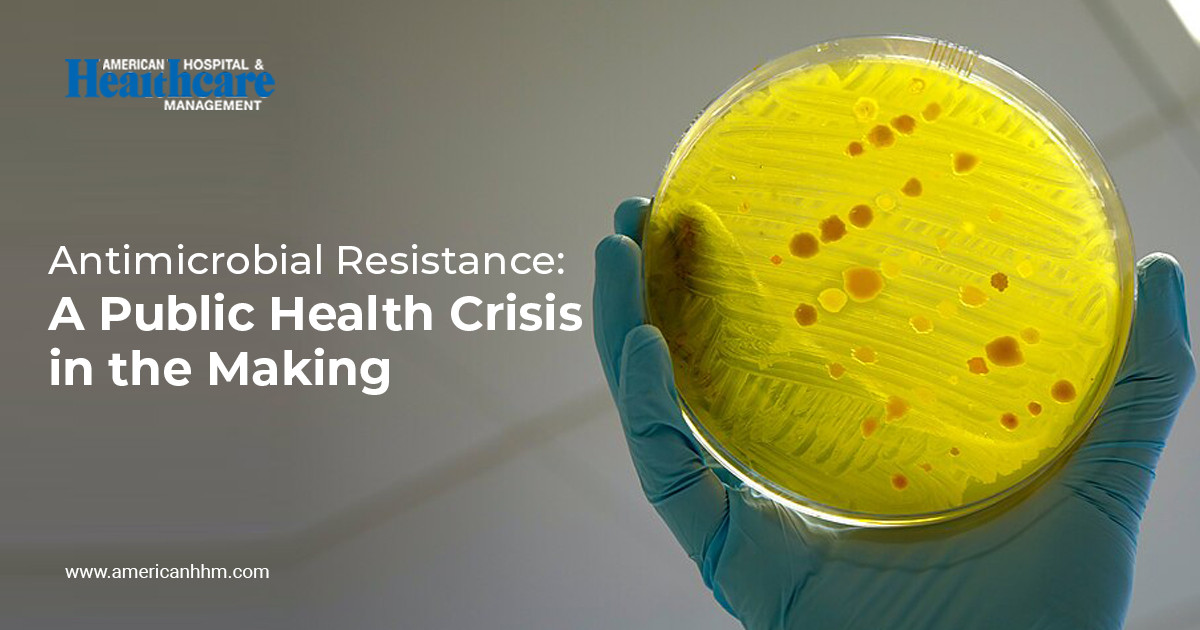
image

Osteoporosis: Causes, Symptoms, Treatment & Supplements Guide
Osteoporosis is often called the “silent bone thief” because bone loss happens gradually and without pain—until a fracture occurs. This condition weakens bones, making them fragile and more likely to break from minor falls or even simple movements.
Complete Guide: https://www.europeanhhm.com/articles/osteoporosis


@Sarah20
Antimicrobial resistance (AMR) poses one of the most severe threats to modern medicine, rendering life-saving antibiotics and other antimicrobial drugs ineffective. This silent pandemic is fueled by the overuse and misuse of these critical medications in humans, animals, and agriculture. The consequences are dire, leading to longer hospital stays, higher medical costs, and increased mortality. Addressing AMR requires a concerted One Health approach, integrating human, animal, and environmental health strategies, alongside global surveillance, robust stewardship programs, and accelerated research into novel antibiotics and alternative therapies.
To gain a comprehensive understanding of the causes, impacts, and multifaceted solutions to this pressing crisis, visit the in-depth resource on Antimicrobial Resistance: A Public Health Crisis(https://www.americanhhm.com/me....dical-sciences/antim
For more expert analysis and articles on the latest developments in healthcare, explore the main hub at American Hospital & Healthcare Management(https://www.americanhhm.com/). To read further on a wide array of medical science topics, be sure to visit their dedicated Medical Sciences section(https://www.americanhhm.com/medical-sciences).
Ground Your Healthcare Strategy in Evidence-Based Research
Move beyond surface-level insight. Leverage research that drives action.
➤ Access and download our library of authoritative healthcare whitepapers here:
https://www.americanhhm.com/whitepapers

Beyond the Headlines: Access Actionable Healthcare Insights for European Leaders
Elevate your expertise with content that matters. Explore a wealth of actionable knowledge today.
➤ Dive into the European HHM articles library and access our latest research here:
https://www.europeanhhm.com/articles

Unlock Expert Insights in the Latest Issue of Asianhhm Magazine — Issue 69 Now: https://www.asianhhm.com/magazine
#healthcaremagazine #healthcareprofessionals







